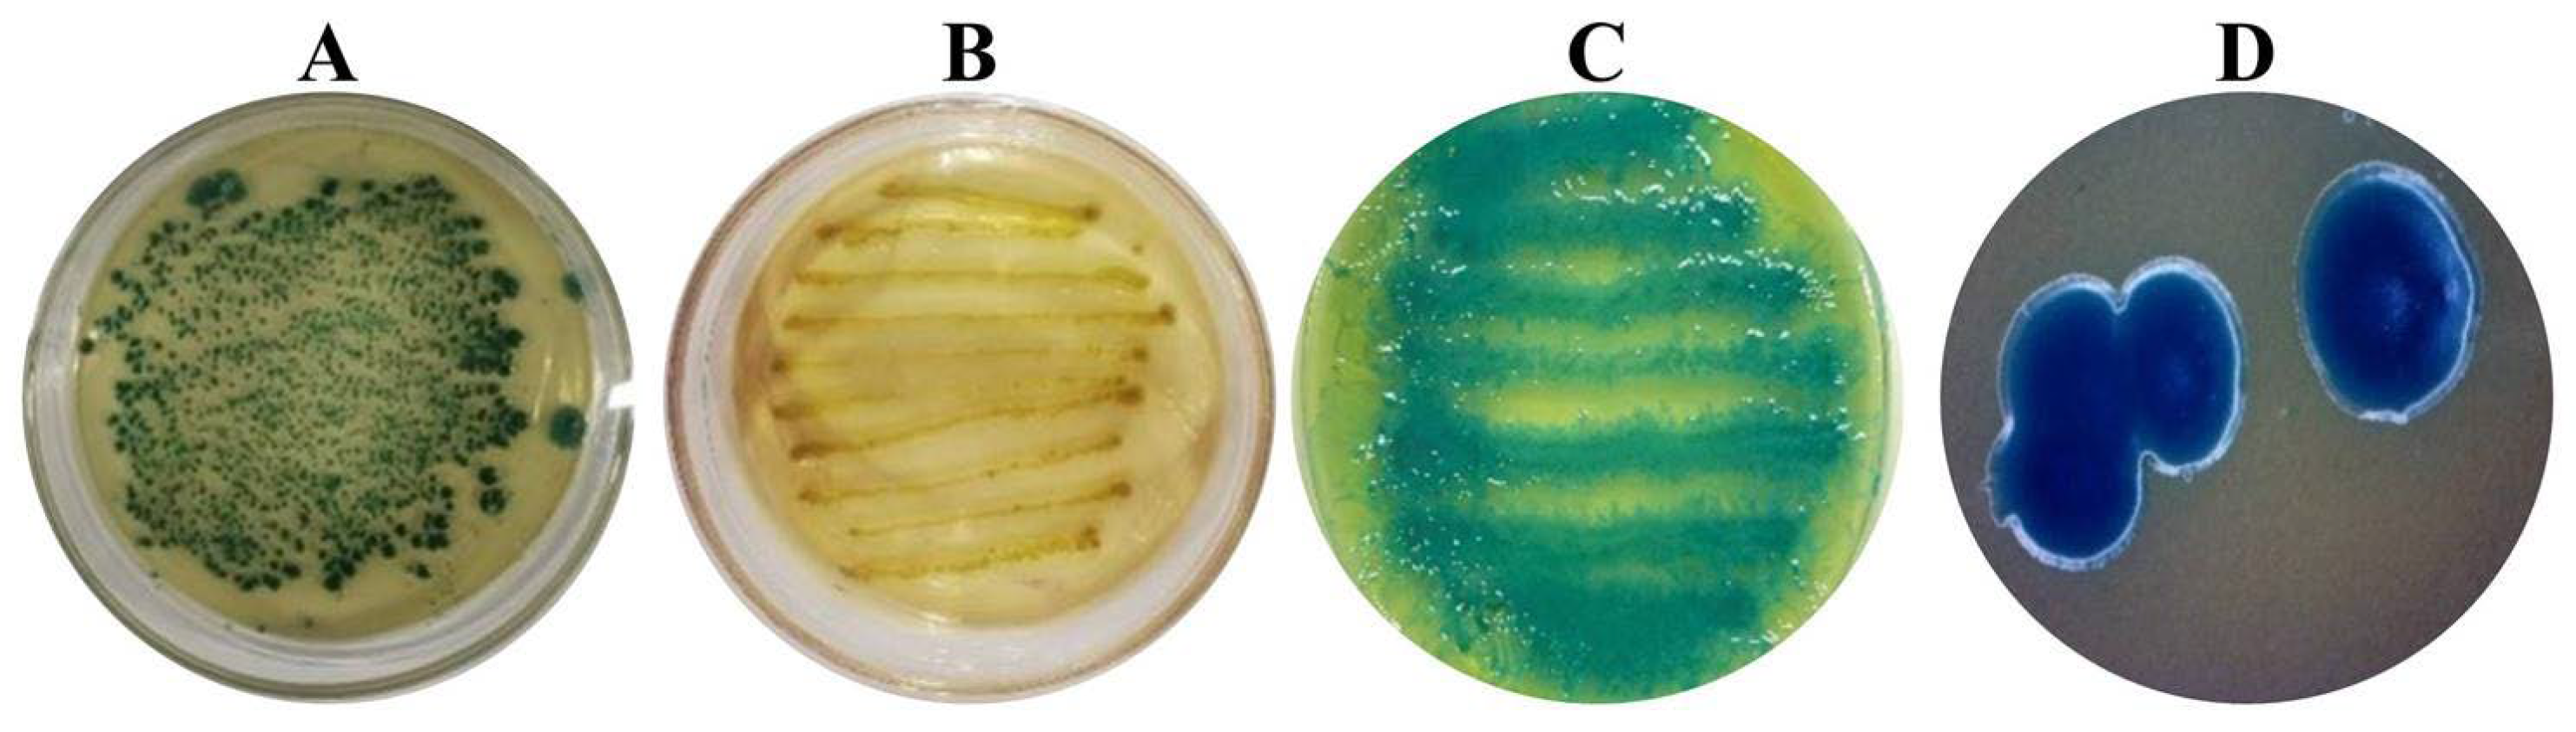

Pathogenicity of Steinernema carpocapsae ALL Entomopathogenic Nematodes and Their Symbiotic Bacteria as a Biological Control Agent on Red Palm Weevil
Abstract
1. Introduction
2. Materials and Methods
2.1. Rearing and Propagation of Red Palm Weevil and Entomopathogenic Nematodes
2.2. Evaluation of Steinernema carpocapsae on the Third-Instar of RPW Larvae
2.3. Preparation of Culture Medium of Nematode Symbiotic Bacteria
2.4. Identification of Nematode Symbiotic Bacteria
2.5. Toxicity of Nematode Symbiotic Bacteria Against RPW Adult Through Feeding
2.6. Toxicity of Symbiotic Bacteria on the Third-Instar RPW Larvae via the Feeding
2.7. Toxicity of Symbiotic Bacteria on the Third-Instar RPW Larvae via the Injection
2.8. Data Analysis
3. Results
3.1. The Pathogenicity Evaluation of S. carpocapsae on the Third-Instar RPW Larvae
3.2. Morphological Characteristics of Symbiotic Bacteria Strains from Steinernema carpocapsae ALL
3.3. Taxonomic Identification of Symbiotic Bacteria
3.4. Toxicity of Strain LZ-G7 Following Ingestion by Adult RPW
3.5. Toxicity of Strain LZ-G7 Following Ingestion by Larvae of RPW
3.6. Toxicity of LZ-G7 Strain After Injection into RPW Larvae at the Third-Instar
4. Discussion
5. Conclusions
Author Contributions
Funding
Institutional Review Board Statement
Informed Consent Statement
Data Availability Statement
Conflicts of Interest
References
- Kurdi, H.; Al-Aldawsari, A.; Al-Turaiki, I.; Aldawood, A.S. Early Detection of Red Palm Weevil, Rhynchophorus ferrugineus (Olivier), Infestation Using Data Mining. Plants 2021, 10, 95. [Google Scholar] [CrossRef] [PubMed]
- Manee, M.M.; Alqahtani, F.H.; Al-Shomrani, B.M.; El-Shafie, H.A.F.; Dias, G.B. Omics in the Red Palm Weevil Rhynchophorus ferrugineus (Olivier) (Coleoptera: Curculionidae): A Bridge to the Pest. Insects 2023, 14, 255. [Google Scholar] [CrossRef] [PubMed]
- Ge, X.; He, S.; Wang, T.; Yan, W.; Zong, S. Potential Distribution Predicted for Rhynchophorus ferrugineus in China under Different Climate Warming Scenarios. PLoS ONE 2015, 10, e0141111. [Google Scholar] [CrossRef]
- Sabbahi, R.; Hock, V. Entomopathogenic Fungi against the Red Palm Weevil: Lab and Field Evidence. Crop Prot. 2024, 177, 106566. [Google Scholar] [CrossRef]
- Naveed, H.; Andoh, V.; Islam, W.; Chen, L.; Chen, K. Sustainable Pest Management in Date Palm Ecosystems: Unveiling the Ecological Dynamics of Red Palm Weevil (Coleoptera: Curculionidae) Infestations. Insects 2023, 14, 859. [Google Scholar] [CrossRef] [PubMed]
- Abdel-Baky, N.F.; Aldeghairi, M.A.; Motawei, M.I.; Al-Shuraym, L.A.M.; Al-Nujiban, A.A.S.; Alharbi, M.T.M.; Rehan, M. Monitoring of Infestation Percentages of the Invasive Red Palm Weevil, Rhynchophorus ferrugineus (Coleoptera: Curculionidae), and Management Tactics: A Six-Year Study. Braz. J. Biol. 2022, 82, e263707. [Google Scholar] [CrossRef]
- Delalieux, S.; Hardy, T.; Ferry, M.; Gomez, S.; Kooistra, L.; Culman, M.; Tits, L. Red Palm Weevil Detection in Date Palm Using Temporal UAV Imagery. Remote Sens. 2023, 15, 1380. [Google Scholar] [CrossRef]
- Azmi, W.A.; Lian, C.J.; Zakeri, H.A.; Yusuf, N.; Omar, W.B.; Wai, Y.K.; Zulkefli, A.N.; Husasin, M.H. The Red Palm Weevil, Rhynchophorus ferrugineus: Current Issues and Challenges in Malaysia. Oil Palm Bull. 2017, 74, 17–24. [Google Scholar]
- Al-Zyoud, F.; Shibli, R.; Ghabeish, I. Current Status, Challenges, Management and Future Perspectives of the Red Palm Weevil Rhynchophorus ferrugineus Olivier (Coleoptera, Curculionidae) Eradication—A Review. J. Exp. Biol. Agric. Sci. 2021, 9, 697–714. [Google Scholar] [CrossRef]
- Sallam, A.A.; El-Shafie, H.A.F.; Al-Abdan, S. Influence of Farming Practices on Infestation by Red Palm Weevil Rhynchophorus ferrugineus (Olivier) in Date Palm: A Case Study. Int. Res. J. Agric. Sci. Soil Sci. 2012, 2, 370–376. [Google Scholar]
- Ahmad, M.F.; Ahmad, F.A.; Alsayegh, A.A.; Zeyaullah, M.; AlShahrani, A.M.; Muzammil, K.; Saati, A.A.; Wahab, S.; Elbendary, E.Y.; Kambal, N.; et al. Pesticides Impacts on Human Health and the Environment with Their Mechanisms of Action and Possible Countermeasures. Heliyon 2024, 10, e29128. [Google Scholar] [CrossRef] [PubMed]
- Zhou, W.; Li, M.; Achal, V. A Comprehensive Review on Environmental and Human Health Impacts of Chemical Pesticide Usage. Emerg. Contam. 2025, 11, 100410. [Google Scholar] [CrossRef]
- Jalinas, J.; Lopez-Moya, F.; Marhuenda-Egea, F.C.; Lopez-Llorca, L.V. Beauveria bassiana (Hypocreales: Clavicipitaceae) Volatile Organic Compounds (VOCs) Repel Rhynchophorus ferrugineus (Coleoptera: Dryophthoridae). J. Fungi 2022, 8, 843. [Google Scholar] [CrossRef] [PubMed]
- Lei, C.J.; Ahmad, R.H.I.R.; Halim, N.A.; Asib, N.; Zakaria, A.; Azmi, W.A. Bioefficacy of an Oil-Emulsion Formulation of Entomopathogenic Fungus, Metarhizium anisopliae against Adult Red Palm Weevil, Rhynchophorus ferrugineus. Insects 2023, 14, 482. [Google Scholar] [CrossRef]
- Lei, C.J.; Halim, N.A.; Asib, N.; Zakaria, A.; Azmi, W.A. Conidial Emulsion Formulation and Thermal Storability of Metarhizium anisopliae against Red Palm Weevil, Rhynchophorusferrugineus Olivier (Coleoptera: Dryophthoridae). Microorganisms 2022, 10, 1460. [Google Scholar] [CrossRef]
- Sabbour, M.M.; Solieman, N.Y. Preliminary Investigations into the Biological Control of Red Palm Weevil Rhynchophorus ferrugineus by Using Three Isolates of the Fungus Lecanicillium (Verticillium) Lecanii in Egypt. Int. J. Sci. Res. 2014, 3, 2060–2066. [Google Scholar] [CrossRef]
- Yang, T.H.; Wu, L.H.; Liao, C.T.; Li, D.; Young Shin, T.; Su Kim, J.; Nai, Y.S. Entomopathogenic Fungi-Mediated Biological Control of the Red Palm Weevil Rhynchophorus ferrugineus. J. Asia. Pac. Entomol. 2023, 26, 102037. [Google Scholar] [CrossRef]
- Nicoletti, R.; Becchimanzi, A. Endophytism of Lecanicillium and Akanthomyces. Agriculture 2020, 10, 205. [Google Scholar] [CrossRef]
- Binda-Rossetti, S.; Mastore, M.; Protasoni, M.; Brivio, M.F. Effects of an Entomopathogen Nematode on the Immune Response of the Insect Pest Red Palm Weevil: Focus on the Host Antimicrobial Response. J. Invertebr. Pathol. 2016, 133, 110–119. [Google Scholar] [CrossRef]
- Satheeja Santhi, V.; Salame, L.; Nakache, Y.; Koltai, H.; Soroker, V.; Glazer, I. Attraction of Entomopathogenic Nematodes Steinernema carpocapsae and Heterorhabditis bacteriophora to the Red Palm Weevil (Rhynchophorus ferrugineus). Biol. Control 2015, 83, 75–81. [Google Scholar] [CrossRef]
- Neira-Monsalve, E.; Wilches-Ramírez, N.C.; Terán, W.; del Pilar Márquez, M.; Mosquera-Espinosa, A.T.; Sáenz-Aponte, A. Isolation, Identification, and Pathogenicity of Steinernema carpocapsae and Its Bacterial Symbiont in Cauca-Colombia. J. Nematol. 2021, 52, e2020-89. [Google Scholar] [CrossRef] [PubMed]
- Ramakrishnan, J.; Salame, L.; Nasser, A.; Glazer, I.; Ment, D. Survival and Efficacy of Entomopathogenic Nematodes on Exposed Surfaces. Sci. Rep. 2022, 12, 4629. [Google Scholar] [CrossRef]
- Askary, T.H.; Abd-Elgawad, M.M.M. Opportunities and Challenges of Entomopathogenic Nematodes as Biocontrol Agents in Their Tripartite Interactions. Egypt. J. Biol. Pest Control 2021, 31, 42. [Google Scholar] [CrossRef]
- Julià, I.; Seco de Herrera, M.; Morton, A.; Garriga, A.; Tapia, D.; Navarro-Rocha, J.; Garcia-del-Pino, F. Compatibility of Entomopathogenic Nematodes and Essential Oils: A New Step for Integrated Pest Management of the Truffle Beetle. Biol. Control 2024, 190, 105462. [Google Scholar] [CrossRef]
- Khairuddin, W.; Noor, S. Potential of Entomopathogenic Nematodes As a Biological. Insects 2016, 2, 121. [Google Scholar]
- Thanwisai, A.; Muangpat, P.; Meesil, W.; Janthu, P.; Dumidae, A.; Subkrasae, C.; Ardpairin, J.; Tandhavanant, S.; Yoshino, T.P.; Vitta, A. Entomopathogenic Nematodes and Their Symbiotic Bacteria from the National Parks of Thailand and Larvicidal Property of Symbiotic Bacteria against Aedes aegypti and Culex Quinquefasciatus. Biology 2022, 11, 1658. [Google Scholar] [CrossRef] [PubMed]
- Tarasco, E.; Fanelli, E.; Salvemini, C.; El-Khoury, Y.; Troccoli, A.; Vovlas, A.; De Luca, F. Entomopathogenic Nematodes and Their Symbiotic Bacteria: From Genes to Field Uses. Front. Insect Sci. 2023, 3, 1195254. [Google Scholar] [CrossRef]
- Tomar, P.; Thakur, N.; Yadav, A.N. Endosymbiotic Microbes from Entomopathogenic Nematode (EPNs) and Their Applications as Biocontrol Agents for Agro-Environmental Sustainability. Egypt. J. Biol. Pest Control 2022, 32, 80. [Google Scholar] [CrossRef]
- Matuska-Łyżwa, J.; Duda, S.; Nowak, D.; Kaca, W. Impact of Abiotic and Biotic Environmental Conditions on the Development and Infectivity of Entomopathogenic Nematodes in Agricultural Soils. Insects 2024, 15, 421. [Google Scholar] [CrossRef]
- Gulcu, B.; Cimen, H.; Raja, R.K.; Hazir, S. Entomopathogenic Nematodes and Their Mutualistic Bacteria: Their Ecology and Application as Microbial Control Agents. Biopestic. Int. 2017, 13, 79–112. [Google Scholar]
- Kenney, E.; Eleftherianos, I. Entomopathogenic and Plant Pathogenic Nematodes as Opposing Forces in Agriculture. Int. J. Parasitol. 2016, 46, 13–19. [Google Scholar] [CrossRef] [PubMed]
- Rehman, G.; Mamoon-ur-Rashid, M. Evaluation of Entomopathogenic Nematodes against Red Palm Weevil, Rhynchophorus ferrugineus (Olivier) (Coleoptera: Curculionidae). Insects 2022, 13, 733. [Google Scholar] [CrossRef] [PubMed]
- Cappa, F.; Torrini, G.; Mazza, G.; Inghilesi, A.F.; Benvenuti, C.; Viliani, L.; Roversi, P.F.; Cervo, R. Assessing Immunocompetence in Red Palm Weevil Adult and Immature Stages in Response to Bacterial Challenge and Entomopathogenic Nematode Infection. Insect Sci. 2020, 27, 1031–1042. [Google Scholar] [CrossRef]
- Husain, M.; Rasool, K.G.; Sutanto, K.D.; Omer, A.O.; Tufail, M.; Aldawood, A.S. Laboratory Evaluation of Indigenous and Commercial Entomopathogenic Nematodes against Red Palm Weevil, Rhynchophorus ferrugineus (Coleoptera: Curculionidae). Insects 2024, 15, 290. [Google Scholar] [CrossRef] [PubMed]
- Myers, P.B.; Gilligan, G.M. Mechanism of Buffer Action In Soils. Science 1927, 66, 302. [Google Scholar] [CrossRef]
- Xu, W.; Huang, F.S.; Hao, H.X.; Duan, J.H.; Qiu, Z.W. Two Serine Proteases from Anopheles Dirus Haemocytes exhibit Changes in Transcript Abundance after Infection of an Incompatible Rodent Malaria Parasite, Plasmodium Yoelii. Vet. Parasitol. 2006, 139, 93–101. [Google Scholar] [CrossRef]
- Zhong, B.; Lv, C.; Li, W.; Li, C.; Chen, T. Virulence of Entomopathogenic Bacteria Serratia marcescens against the Red Palm Weevil, Rhynchophorus ferrugineus (Olivier). PeerJ 2023, 11, e16528. [Google Scholar] [CrossRef]
- Baozhu, Z.; Xiaodong, S.; Chaojun, L.; Chaoxu, L.; Weiquan, Q. Isolation and Identification of Metarhizium anisopliae from Red Palm Weevil and Its Pathogenicity on Coconut Spike Moth. China Plant Prot. 2021, 41, 21–26. [Google Scholar]
- Soares, S.; Amaral, J.S.; Oliveira, M.B.P.P.; Mafra, I. Improving DNA Isolation from Honey for the Botanical Origin Identification. Food Control 2015, 48, 130–136. [Google Scholar] [CrossRef]
- Abdelsalam, S.A.; Alzahrani, A.M.; Elmenshawy, O.M.; Abdel-Moneim, A.M. Spinosad Induces Antioxidative Response and Ultrastructure Changes in Males of Red Palm Weevil Rhynchophorus ferrugineus (Coleoptera: Dryophthoridae). J. Insect Sci. 2016, 16, 106. [Google Scholar] [CrossRef][Green Version]
- Qin, L.; Lixin, H.; Yurong, L.; Guangjie, H.; Chuanming, L.; Yang, X.; Jianhang, Q.; Jian, X. Infecting and Toxic Effect of Steinernema carpocapsa N-Yz1 to Fall Armyworm, Spodoptera frugiperda LIU. Chin. J. Biol. Control 2023, 39, 542–549. [Google Scholar] [CrossRef]
- Huang, J.; Wu, W.-J. Calculate the Median Lethal Dose and Chi Square Test with EXCEL in Toxicological Tests. Entomol. Knowl. 2004, 41, 594–598. [Google Scholar]
- Han, W.S.; Wang, Z.R.; Liu, Y.; Gao, J.L.; Zhao, D.X.; Zhong, Y.H.; Zhao, S. Effects Evaluation of Different Entomopathogenic Nematode Strains Against Aethina tumida (Coleoptera: Nitidulidae). Chin. J. Trop. Crop. 2021, 42, 1402–1408. [Google Scholar] [CrossRef]
- Chen, Q.X.; Liu, Q.Z.; Cao, J.F.; Wei, T.Y.; Shi, Y.; Guo, L. Evaluation of Two Entomopathogenic Nematode Species for Control of Batocera lineolata on Walnut Trees. Chin. J. Biol. Control 2016, 32, 456–461. [Google Scholar] [CrossRef]
- Triggiani, O.; Tarasco, E. Evaluation of the Effects of Autochthonous and Commercial Isolates of Steinernematidae and Heterorhabditidae on Rhynchophorus ferrugineus. Bull. Insectol. 2011, 64, 175–180. [Google Scholar]
- El Sadawy, H.A.; EL Namaky, A.H.; Al Omari, F.; Bahareth, O.M. Susceptibility of Rhynchophorus ferrugineus (Olivier) (Coleoptera: Curculionidae) to Entomopathogenic Nematodes with Regard to Its Immune Response. Biol. Control 2020, 148, 104308. [Google Scholar] [CrossRef]
- Manzoor, M.; Ahmad, J.N.; Sharif, M.Z.; Jafir, M.; Ali, H.; Majeed, D.; Kiran, H. Comparative Effectiveness of Entomopathogenic Nematodes against Red Palm Weevil (Rhynchophorus ferrugineus) in Pakistan. J. Entomol. Zool. Stud. 2017, 5, 756–760. [Google Scholar]
- Almasoudi, N.M.; Asiry, K.A.; Abo-Elyousr, K.A.M. Isolation, Identification and Efficacy of Three Bacterial Isolates against the Red Palm Weevil, Rhynchophorus ferrugineus (Olivier) (Coleoptera: Curculionidae). Egypt. J. Biol. Pest Control 2022, 32, 52. [Google Scholar] [CrossRef]

| LB Culture Medium | NBTA Culture Medium | NA Culture Medium | M Culture Medium | ||||
|---|---|---|---|---|---|---|---|
| Component | Content | Component | Content | Component | Content | Component | Content |
| Tryptone | 10.0 g/L | Beef extract | 5.0 g/L | Beef extract | 5.0 g/L | Glucose | 6.0 g/L |
| Yeast Extract | 5.0 g/L | Peptone | 10.0 g/L | Peptone | 10.0 g/L | Peptone | 20.0 g/L |
| NaCl | 10.0 g/L | NaCl | 5.0 g/L | Dd H2O | 1.0 L | MgSO4 | 1.4 g/L |
| Agar | 18.0 g/L | Agar | 18.0 g/L | pH | 7.0 | KH2PO4 | 0.72 g/L |
| dd H2O | 1.0 L | Bromothymol Blue | 0.025 g/L | K2HPO4 | 0.98 g/L | ||
| pH | 7.0 | Red tetrazolium | 0.04 g/L | dd H2O | 1.0 L | ||
| dd H2O | 1.0 L | pH | 7.0 | ||||
| pH | 7.0 | ||||||
| Reaction System (50 μL) | Amplification Procedure | ||||
|---|---|---|---|---|---|
| Regent | Amounts (μL) | Steps | Temperature | Time | Cycle |
| DNA polymerase 2xTaq PCR MasterMixII | 25 | pre-denaturation | 94 °C | 5 min | - |
| Upstream primer | 1 | Denaturation | 94 °C | 30 s | 35 |
| Downstream primer | 1 | Annealing | 55 °C | 30 s | 35 |
| DNA templates | 4 | Extension | 72 °C | 90 s | 35 |
| ddH2O | 19 | Final extension | 72 °C | 10 min | - |
| Store | 4 °C | Forever | - | ||
| Exposure Time | LC50 (IJs/mL) | 95% Confidence Interval | Concentration (IJs/mL) | LT50 (h) | 95% Confidence Interval |
|---|---|---|---|---|---|
| 24 h | 1139 | 380–3411.60 | 50 | 96.99 | 84.10–111.90 |
| 48 h | 173.40 | 128.89–233 | 100 | 84.31 | 74.10–95.96 |
| 72 h | 94.57 | 75.20–119.30 | 150 | 66.81 | 59.40–75.14 |
| 96 h | 69.18 | 53.54–89.40 | 200 | 49.29 | 44.20–54.97 |
| 120 h | 57.67 | 44.40–74.90 | 250 | 45.03 | 40.60–49.96 |
| Time | LC50 (CFU/mL) | 95% Confidence Interval | Concentration (CFU/mL) | LT50 (h) | 95% Confidence Interval |
|---|---|---|---|---|---|
| 6 h | 185.00 × 109 | 1.95 × 108–1.74 × 1014 | 0.01 × 107 | 186.13 | 79.18–437.6 |
| 12 h | 18.000 × 109 | 2.83 × 108–1.14 × 1012 | 0.10 × 107 | 181.29 | 40.48–811.9 |
| 24 h | 9.9500 × 109 | 3.63 × 108–2.72 × 1011 | 1.00 × 107 | 166.52 | 68.91–402.4 |
| 36 h | 1.7000 × 109 | 1.64 × 108–1.75 × 1010 | 5.00 × 107 | 103.27 | 54.45–195.8 |
| 48 h | 0.0457 × 109 | 1.90 × 107–1.10 × 108 | 10.0 × 107 | 37.450 | 29.80–47.07 |
| Time | LC50 (CFU/g) | 95% Confidence Interval | Concentration (CFU/mL) | LT50 (h) | 95% Confidence Interval |
|---|---|---|---|---|---|
| 24 h | 0.99 × 108 | 0.43 × 108–2.25 × 108 | 0.10 × 108 | 206.77 | 139.80–305.60 |
| 48 h | 0.34 × 108 | 0.28 × 108–0.41 × 108 | 0.15 × 108 | 116.37 | 97.10–139.50 |
| 72 h | 0.24 × 108 | 0.21 × 108–0.27 × 108 | 0.20 × 108 | 100.84 | 86.13–118.10 |
| 96 h | 0.18 × 108 | 0.17 × 108–0.20 × 108 | 0.25 × 108 | 83.96 | 73.81–95.50 |
| 120 h | 0.15 × 108 | 0.14 × 108–0.17 × 108 | 0.30 × 108 | 48.48 | 43.37–54.18 |
| Time | LD50 (CFU) | 95% Confidence Interval | Amount of Injected Bacteria (CFU) | LT50 (h) | 95% Confidence Interval |
|---|---|---|---|---|---|
| 6 h | 76.58 × 106 | 13.70 × 106–427.90 × 106 | 0.5 × 106 | 59.29 | 42.32–83.05 |
| 12 h | 7.77 × 106 | 5.11 × 106–11.81 × 106 | 2 × 106 | 29.37 | 23.73–36.36 |
| 24 h | 3.03 × 106 | 2.38 × 106–3.86 × 106 | 4 × 106 | 19.41 | 16.57–22.73 |
| 36 h | 1.34 × 106 | 0.96 × 106–1.87 × 106 | 6 × 106 | 16.89 | 14.69–19.41 |
| 48 h | 0.63 × 106 | 0.40 × 106–1.00 × 106 | 8 × 106 | 11.10 | 09.32–13.22 |
Disclaimer/Publisher’s Note: The statements, opinions and data contained in all publications are solely those of the individual author(s) and contributor(s) and not of MDPI and/or the editor(s). MDPI and/or the editor(s) disclaim responsibility for any injury to people or property resulting from any ideas, methods, instructions or products referred to in the content. |
© 2025 by the authors. Licensee MDPI, Basel, Switzerland. This article is an open access article distributed under the terms and conditions of the Creative Commons Attribution (CC BY) license (https://creativecommons.org/licenses/by/4.0/).
Share and Cite
Lv, C.; Meng, T.; Zhong, B.; Shang, Z.; Li, C.; Zahra, A.A.; Abdelrahman, T.M. Pathogenicity of Steinernema carpocapsae ALL Entomopathogenic Nematodes and Their Symbiotic Bacteria as a Biological Control Agent on Red Palm Weevil. Microorganisms 2025, 13, 971. https://doi.org/10.3390/microorganisms13050971
Lv C, Meng T, Zhong B, Shang Z, Li C, Zahra AA, Abdelrahman TM. Pathogenicity of Steinernema carpocapsae ALL Entomopathogenic Nematodes and Their Symbiotic Bacteria as a Biological Control Agent on Red Palm Weevil. Microorganisms. 2025; 13(5):971. https://doi.org/10.3390/microorganisms13050971
Chicago/Turabian StyleLv, Chaojun, Taigao Meng, Baozhu Zhong, Zhongqiu Shang, Chaoxu Li, Abdullah A. Zahra, and Talat M. Abdelrahman. 2025. "Pathogenicity of Steinernema carpocapsae ALL Entomopathogenic Nematodes and Their Symbiotic Bacteria as a Biological Control Agent on Red Palm Weevil" Microorganisms 13, no. 5: 971. https://doi.org/10.3390/microorganisms13050971
APA StyleLv, C., Meng, T., Zhong, B., Shang, Z., Li, C., Zahra, A. A., & Abdelrahman, T. M. (2025). Pathogenicity of Steinernema carpocapsae ALL Entomopathogenic Nematodes and Their Symbiotic Bacteria as a Biological Control Agent on Red Palm Weevil. Microorganisms, 13(5), 971. https://doi.org/10.3390/microorganisms13050971

